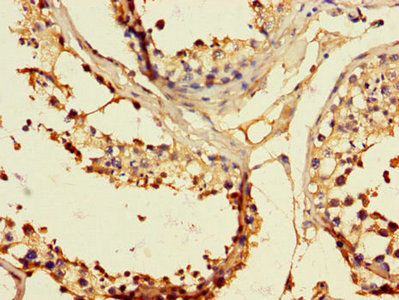

EPHB2 Antibody
-
中文名稱:EPHB2兔多克隆抗體
-
貨號:CSB-PA007730LA01HU
-
規格:¥440
-
圖片:
-
其他:
產品詳情
-
產品名稱:Rabbit anti-Homo sapiens (Human) EPHB2 Polyclonal antibody
-
Uniprot No.:
-
基因名:EPHB2
-
別名:cek5 antibody; Developmentally regulated EPH related tyrosine kinase antibody; DRT antibody; EK5 antibody; ELK related protein tyrosine kinase antibody; Eph receptor B2 antibody; EPH tyrosine kinase 3 antibody; EPH-like kinase 5 antibody; EPHB2 antibody; EPHB2_HUMAN antibody; Ephrin type B receptor 2 antibody; Ephrin type-B receptor 2 antibody; EPHT 3 antibody; ERK antibody; ETECK antibody; hEK5 antibody; Nuk antibody; Prkm 5 antibody; Receptor protein tyrosine kinase HEK 5 antibody; Renal carcinoma antigen NY-REN-47 antibody; Sek 3 antibody; Tyro 5 antibody; Tyrosine protein kinase receptor CEK 5 antibody; Tyrosine protein kinase receptor EPH 3 antibody; Tyrosine protein kinase receptor QEK 5 antibody; Tyrosine-protein kinase receptor EPH-3 antibody; Tyrosine-protein kinase TYRO5 antibody
-
宿主:Rabbit
-
反應種屬:Human
-
免疫原:Recombinant Human Ephrin type-B receptor 2 protein (261-465AA)
-
免疫原種屬:Homo sapiens (Human)
-
標記方式:Non-conjugated
本頁面中的產品,EPHB2 Antibody (CSB-PA007730LA01HU),的標記方式是Non-conjugated。對于EPHB2 Antibody,我們還提供其他標記。見下表:
-
克隆類型:Polyclonal
-
抗體亞型:IgG
-
純化方式:>95%, Protein G purified
-
濃度:It differs from different batches. Please contact us to confirm it.
-
保存緩沖液:Preservative: 0.03% Proclin 300
Constituents: 50% Glycerol, 0.01M PBS, PH 7.4 -
產品提供形式:Liquid
-
應用范圍:ELISA, IHC, IF
-
推薦稀釋比:
Application Recommended Dilution IHC 1:20-1:200 IF 1:50-1:200 -
Protocols:
-
儲存條件:Upon receipt, store at -20°C or -80°C. Avoid repeated freeze.
-
貨期:Basically, we can dispatch the products out in 1-3 working days after receiving your orders. Delivery time maybe differs from different purchasing way or location, please kindly consult your local distributors for specific delivery time.
-
用途:For Research Use Only. Not for use in diagnostic or therapeutic procedures.
相關產品
靶點詳情
-
功能:Receptor tyrosine kinase which binds promiscuously transmembrane ephrin-B family ligands residing on adjacent cells, leading to contact-dependent bidirectional signaling into neighboring cells. The signaling pathway downstream of the receptor is referred to as forward signaling while the signaling pathway downstream of the ephrin ligand is referred to as reverse signaling. Functions in axon guidance during development. Involved in the guidance of commissural axons, that form a major interhemispheric connection between the 2 temporal lobes of the cerebral cortex. Also involved in guidance of contralateral inner ear efferent growth cones at the midline and of retinal ganglion cell axons to the optic disk. In addition to axon guidance, also regulates dendritic spines development and maturation and stimulates the formation of excitatory synapses. Upon activation by EFNB1, abolishes the ARHGEF15-mediated negative regulation on excitatory synapse formation. Controls other aspects of development including angiogenesis, palate development and in inner ear development through regulation of endolymph production. Forward and reverse signaling through the EFNB2/EPHB2 complex regulate movement and adhesion of cells that tubularize the urethra and septate the cloaca. May function as a tumor suppressor. May be involved in the regulation of platelet activation and blood coagulation.
-
基因功能參考文獻:
- These findings suggested that miR-204 might serve as a tumor suppressor in the development of cervical cancer by directly targeting EphB2. PMID: 28800788
- EphB2 signaling-mediated Sirt3 expression reduces MSC senescence by maintaining mitochondrial reactive oxygen species homeostasis. PMID: 28687409
- This is the first study to link SLC1A3 and EPHB2 to clinically relevant vertebral osteoporosis phenotypes. PMID: 27476799
- Data show that EPHB2 predicted poor breast cancer survival and EPHB2 protein expression has also prognostic value depending on cell localization. PMID: 26870995
- showed that patients with SSc or SLE have AAb against EphB2, a protein involved in angiogenesis, and THEX1, a 3'-5' exoribonuclease involved in histone mRNA degradation. We have further identified a peptide from EphB2 as a specific and sensitive tool for SLE diagnosis PMID: 27617966
- show that expression of EPHB2 and SNAIL1 - an inducer of epithelial-mesenchymal transition (EMT) - is anti-correlated in colorectal cancer cell lines and tumors PMID: 27504909
- Tiam2/Rac are key components of EphB2 trans-endocytosis and are important for cell repulsion. PMID: 27597758
- High expression of junctional adhesion molecule-A and EphB2 can predict poor overall survival and high mortality rate, and EphB2 is an independent prognostic biomarker in lung adenocarcinoma patients. PMID: 28231727
- Data show that activation of EphB2 receptor kinase arrests tau protein hyperphosphorylation through phosphatidylinositol 3-kinase (PI3K)/Akt protein-mediated glycogen synthase kinase-3beta (GSK-3beta) inhibition. PMID: 26119563
- Expression of the Receptor Tyrosine Kinase EphB2 on Dendritic Cells Is Modulated by Toll-Like Receptor Ligation but Is Not Required for T Cell Activation PMID: 26407069
- Myosin 1 functions as an effector of EphB2/ephrinB signaling, controls cell morphology, and thereby cell repulsion. PMID: 26195670
- EphB2 activation is required for ependymoma development as well as it inhibits differentiation and promotes proliferation of the transformed cell. PMID: 25801123
- The results show an intricate interplay between p53 and TGF-beta3 whereby p53 inhibits the TGF-beta3-induced expression of genes, e.g., EPHB2, to impede tumor cell invasion and migration PMID: 25257729
- loss of EphB2 and gain of EphB4 expression represents an inflection point in the development, growth and possibly progression of TCC. PMID: 25148033
- knockdown impairs monocyte transmigration through the endothelium PMID: 24522257
- the upregulation of EphB2 receptors and its specific ligands leads to cholangiocarcinoma metastasis. PMID: 25012246
- Serrated colorectal carcinoma as proposed to arise from serrated adenoma is characterized by down regulation of EphB2. PMID: 24612059
- Comparative crystalisation analysis of the human EphB family kinases has yielded new crystal forms of the human EphB2 and EphB4 catalytic domains. PMID: 24677421
- EphB2 was involved in human naive B cell activation through Src-p65 and Notch1 signaling pathways and could be regulated by miR-185. PMID: 24803541
- Overexpression of EphB2 is associated with glioma. PMID: 23835497
- EphB2 plays an important role in cervical cancer progression by orchestrating an epithelial-mesenchymal transition program through R-Ras activation. PMID: 24439224
- A mechanism involving a triple role for EphB2 in breast cancer progression, whereby it regulates apoptosis, autophagy, and invasion. PMID: 24211352
- overexpression of Ephrin B2 receptor is associated with malignant mesothelioma. PMID: 23887168
- Mutation of EPHB2 is frequent in colorectal tumors with microsatellite instability. PMID: 24222164
- Marrow stromal cell subpopulations express EphB2 engrafted in the fetal intestinal epithelium when xenografted into sheep PMID: 23413357
- EphB2 silencing increased tumor cell proliferation. PMID: 22310282
- High ephrin-B1 expression is associated with medulloblastoma. PMID: 22723427
- PTPN14 has a role in angiogenesis and/or arteriovenous fate, acting via EphrinB2 and ACVRL1/activin receptor-like kinase 1 PMID: 22233626
- Data indicated for the first time that EphrinB2 and EphB4 expressions increase according to the histopathological grade and KPS score of glioma, and their expression levels are related to the progression-free survival of glioblastoma patients. PMID: 22374425
- Define the transcriptional targets of the reverse signaling by EphB2 acting exclusively as a ligand in epidermal keratinocyte differentiation. PMID: 21809346
- High Eph-B2 is associated with Waldenstrom's macroglobulinemia. PMID: 22010211
- EphB2 is an ephrin receptor and is up-regulated in invasive tumors but its role needs to be confirmed in further cases of Wilms tumors. PMID: 21387540
- EPHB2 interacts with EPHB6 in breast tumor cell lines PMID: 21737611
- data suggest that genetic variation at the EphB2 locus may increase risk of sporadic prostate cancer risk in African American men. PMID: 21603658
- Mutation in EphB2 gene is associated with colorectal adenocarcinoma PMID: 21161727
- at least in the context of pancreatic carcinoma CFPAC-1 cells, EphB2 plays a tumor suppressor role in cell proliferation and apoptosis PMID: 21292437
- Even a moderate level of EphB2 expression has effects on tumour cells which results in reduced migration and invasiveness and slows the growth of colonic tumour implants in an in vivo model. PMID: 20339854
- The MAPK pathway is important in the pro-death action of EphB2, through ERK1/2 phosphorylation and inhibition of this pathway using PD98059 counters EphB2-driven cell death. PMID: 20046096
- RYK, a catalytically inactive receptor tyrosine kinase, associates with EphB2 and EphB3 but does not interact with AF-6. PMID: 11956217
- role of extracellular signal-regulated kinase (ERK) during the differentiation of human monoblastic U937 cells stimulated by granulocyte-macrophage colony-stimulating factor (GM-CSF) and tumor necrosis factor (TNF) PMID: 12063024
- liganded to EFNB1 and EFNB2, expresssed in gastric cancer PMID: 12136247
- Glioma migration and invasion are promoted by activation of EphB2 or inhibited by blocking EphB2. Dysregulation of EphB2 expression or function may underlie glioma invasion. PMID: 15126357
- our findings suggest that mutational inactivation of EPHB2 may be important in the progression and metastasis of prostate cancer. PMID: 15300251
- loss of EphB expression represents a critical step in colorectal cancer progression PMID: 15973414
- Deregulated EphB2 expression may play a role in several cancer types with loss of EphB2 expression serving as an indicator of the possible pathogenetic role of EphB2 signaling in the maintenance of tissue architecture of colon epithelium. PMID: 16166419
- progressive loss of EphB2 expression seen in each critical step of colon carcinogenesis, including the onset of invasion, dedifferentiation and metastasis which are paralleled by adverse patient outcome PMID: 16272170
- These results demonstrate that the MAPK ERK signaling pathway contributes to the p53-independent antiproliferative functions of p14ARF. Furthermore, they identify a new mechanism by which phosphorylation at serine 216 participates to Cdc25C inactivation. PMID: 16582626
- analysis of germline EPHB2 alterations in patients with colorectal tumors PMID: 16740153
- High EPHB2 mutation rate is associated with gastric tumors with microsatellite instability PMID: 16819508
- novel link between EphB forward signaling and SDF-1-induced signaling demonstrates a mechanism for cooperative regulation of endothelial cell movement. PMID: 16840724
顯示更多
收起更多
-
相關疾病:Prostate cancer (PC)
-
亞細胞定位:Cell membrane; Single-pass type I membrane protein. Cell projection, axon. Cell projection, dendrite.
-
蛋白家族:Protein kinase superfamily, Tyr protein kinase family, Ephrin receptor subfamily
-
組織特異性:Brain, heart, lung, kidney, placenta, pancreas, liver and skeletal muscle. Preferentially expressed in fetal brain.
-
數據庫鏈接:
Most popular with customers
-
-
YWHAB Recombinant Monoclonal Antibody
Applications: ELISA, WB, IHC, IF, FC
Species Reactivity: Human, Mouse, Rat
-
Phospho-YAP1 (S127) Recombinant Monoclonal Antibody
Applications: ELISA, WB, IHC
Species Reactivity: Human
-
-
-
-
-